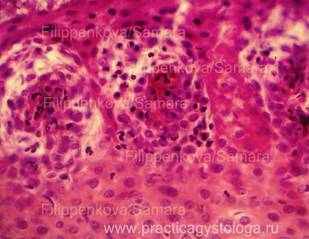

Полезное:
Как сделать разговор полезным и приятным
Как сделать объемную звезду своими руками
Как сделать то, что делать не хочется?
Как сделать погремушку
Как сделать так чтобы женщины сами знакомились с вами
Как сделать идею коммерческой
Как сделать хорошую растяжку ног?
Как сделать наш разум здоровым?
Как сделать, чтобы люди обманывали меньше
Вопрос 4. Как сделать так, чтобы вас уважали и ценили?
Как сделать лучше себе и другим людям
Как сделать свидание интересным?

Категории:
АрхитектураАстрономияБиологияГеографияГеологияИнформатикаИскусствоИсторияКулинарияКультураМаркетингМатематикаМедицинаМенеджментОхрана трудаПравоПроизводствоПсихологияРелигияСоциологияСпортТехникаФизикаФилософияХимияЭкологияЭкономикаЭлектроника

Желудочно-кишечный тракт
|
|
1.Какие представлены слои стенки желудка (слизистая оболочка с многослойным плоским неороговевающим, покровным и железистым эпителием, базальная мембрана, подслизистая основа, мышечная и серозная оболочка, их фрагменты).
2. Степень кровенаполнения сосудов:
- диффузное выраженное и резко выраженное венозно-капиллярное полнокровие, с эритростазами, диапедезными кровоизлияниями, внутрисосудистым лейкоцитозом, внутрипросветным тромбозом, пристеночными тромбами, картиной острого гнойного, продуктивного или полиморфноклеточного васкулита;
- неравномерное кровенаполнение сосудов (одни сосуды в спавшемся состоянии, слабого и умеренного кровенаполнения, другие - полнокровны);
- слабое кровенаполнение (сосуды спавшиеся, с пустыми просветами или содержат небольшое количество крови).
3. Состояние слизистой оболочки (утолщена, истончена, с отёком стромы, наличие некрозов, очаговых или диффузных острой лейкоцитарной инфильтрации, продуктивного воспаления различной степени выраженности, наличие кровоизлияний различного типа и распространенности, клеточная реакция в них, пятна Вишневского - в различных стадиях).
4. Состояние подслизистой основы (утолщена, разрыхлена за счёт отёка, очаговых или диффузных острой лейкоцитарной инфильтрации, продуктивного воспаления различной степени выраженности, с кровоизлияниями различного типа и распространенности, клеточная реакция в них).
5. Состояние мышечной оболочки (в состоянии отёка, с клеточной инфильтрацией, некрозами, кровоизлияниями, замещением гладких мышечных клеток склерозом или атипичной тканью).
6. Состояние серозной оболочки (утолщена, с наличием очаговых или диффузных острой лейкоцитарной инфильтрации, продуктивного воспаления различной степени выраженности, наличие кровоизлияний различного типа и распространенности, клеточная реакция в них, наличие наложений крови, фибрина, гнойно-фибринозного экссудата, наличие туберкулёзных гранулём, гигантских многоядерных макрофагов - клеток Пирогова-Лангганса или клеток инородных тел и др.).
Пример№1.
СТЕНКА ЖЕЛУДКА (2объекта) -выраженное диффузное венозно-капиллярное полнокровие всех слоёв стенки желудка, просветы сосудов расширены, переполнены кровью, с эритростазами, внутрисосудистым лейкоцитозом, пристеночным стоянием лейкоцитов, диапедезными кровоизлияниями. Стенки ряда сосудов с картиной острого гнойного и гнойно-некротического васкулита. Явление внутрипросветного и пристеночного тромбоза. В срезах представлены резко изменённая слизистая оболочка: утолщена, с субтотальным её некрозом, выраженной реактивной лейкоцитарной инфильтрацией, наличием мелких колоний бактериальной микрофлоры, в одном из объектов - резко выраженные очагово-диффузные деструктивные кровоизлияния тёмно-красного и буро-коричневого цвета, с неравномерно выраженным гемолизом эритроцитов на фоне лейкоцитарной инфильтрации. Подслизистая основа резко утолщена, разрыхлена, разволокнена за счёт отёка, с выраженными кровоизлияниями деструктивного характера, с лейкоцитарной инфильтрацией, сливающимися друг с другом, распространяющимися частично на мышечную оболочку. Видны мелкие и средней величины очаги некроза мышечной оболочки с лейкоцитарной инфильтрацией. Серозная оболочка умеренно утолщена, разрыхлена, с немногочисленными сегментоядерными нейтрофильными лейкоцитами, очаговыми тонкими наложениями рыхлого фибрина.

| 
|
| Рис. 1, 2. Картина каррозивно-геморрагического и гнойно-некротического гастрита с выраженным геморрагическим компонентом. Окраска: гематоксилин и эозин. Увеличение х 100 и х 250. |
Пример№2
СТЕНКА ПИЩЕВОДА (1объект) - резко выраженное диффузное венозно-капиллярное полнокровие всех слоёв стенки пищевода, просветы сосудов расширены, переполнены кровью, с эритростазами, внутрисосудистым лейкоцитозом, пристеночным стоянием лейкоцитов, диапедезными кровоизлияниями. Слизистая оболочка резко утолщена, с очаговыми её некрозом и геморрагическим пропитыванием, лейкоцитарной инфильтрацией. Эпителиоциты слизистой оболочки резко набухшие. с выраженным просветлением цитоплазмы, в состоянии резко выраженной гидропической дистрофии. Подслизистая основа в состоянии резко выраженного отёка, с наличием сливающихся диапедезно-деструктивных кровоизлияний тёмно-красного цвета, с неравномерным гемолизом эритроцитов, лейкоцитарной инфильтрацией, распространяющейся на мышечную оболочку. Серозная оболочка в данных срезах не представлена.

| 
|
| Рис. 3-5. Картина гнойно-некротического эзофагита с выраженным геморрагическим компонентом. Окраска: гематоксилин и эозин. Увеличение х 100 и х 250. |
Государственное учреждение здравоохранения
«САМАРСКОЕ ОБЛАСТНОЕ БЮРО СУДЕБНО-МЕДИЦИНСКОЙ ЭКСПЕРТИЗЫ»
К «Акту судебно-гистологического исследования» № 09-8/ ХХХ 2008 год
Таблица № 1
Рис. 1-4. Грибковое поражение пищевода, предположительно, кандидозной природы. Слизистая оболочка в состоянии некроза, практически не прослеживается, на её месте выраженное разрастание мицелия гриба с наличием дрожжеподобных округло-овальных тел. Мицелярные нити (гифы) тянутся от базальной мембраны в виде густого «частокола». В подслизистой основе и частично в мышечной оболочке на фоне резко выраженного отёка, между утолщенными, разрыхленными, расщеплёнными соединительнотканными волокнами расположены элементы гриба, макрофаги, фибробласты и круглоклеточные элементы. Окраска: гематоксилин и эозин. Увеличение х 100, х 250, х 400. Отдельные микрофотографии проведены при закрытой диафрагме (1, 2, 4), элементы гриба в них отблескивают.

| 
|

| 
|
Судебно-медицинский эксперт Филиппенкова Е. И.
Государственное учреждение здравоохранения
«САМАРСКОЕ ОБЛАСТНОЕ БЮРО СУДЕБНО-МЕДИЦИНСКОЙ ЭКСПЕРТИЗЫ»
К «Заключению эксперта» № 09-8/ ХХХ 2007 год
Таблица № 2

| Рис. 1. СТЕНКА ТОНКОЙ КИШКИ- выраженное диффузное венозно-капиллярное полнокровие, эритростазы, диапедезные микрогеморрагии.На всём протяжении срезов серозная оболочка умеренно утолщена, с наличием полиморфноклеточного воспаления с преобладанием продуктивного компонента (сочетание круглоклеточных элементов, макрофагов, гистиоцитов, умеренной пролиферации соединительнотканных элементов, с включениями уплотнённого фибрина). Отдельные сосуды с картиной полиморфноклеточного васкулита. Картина полиморфноклеточного перитонита с преобладанием продуктивного компонента. Окраска: гематоксилин и эозин. Увеличение х 250. |

| Рис. 2. В срезах одного из объектов представлен полосовидный фрагмент жировой клетчатки с тонкими прослойками волокнистой соединительной ткани, группами полнокровных сосудов, по краю срезов - неширокий полосовидный фрагмент волокнистой соединительной ткани с признаками выраженного полиморфноклеточного воспаления с преобладанием продуктивного компонента (стрелка). На поверхности соединительной ткани распространённые умеренно выраженные полосовидные наложения компактно расположенных эритроцитарных масс тёмно-красного цвета, с очаговым неравномерным гемолизом эритроцитов, небольшим и умеренным количеством лейкоцитов, тонким нитевидным включением рыхлого фибрина. Окраска: гематоксилин и эозин. Увеличение х 100. |
Судебно-медицинский эксперт Филиппенкова Е. И.

Date: 2015-07-01; view: 645; Нарушение авторских прав